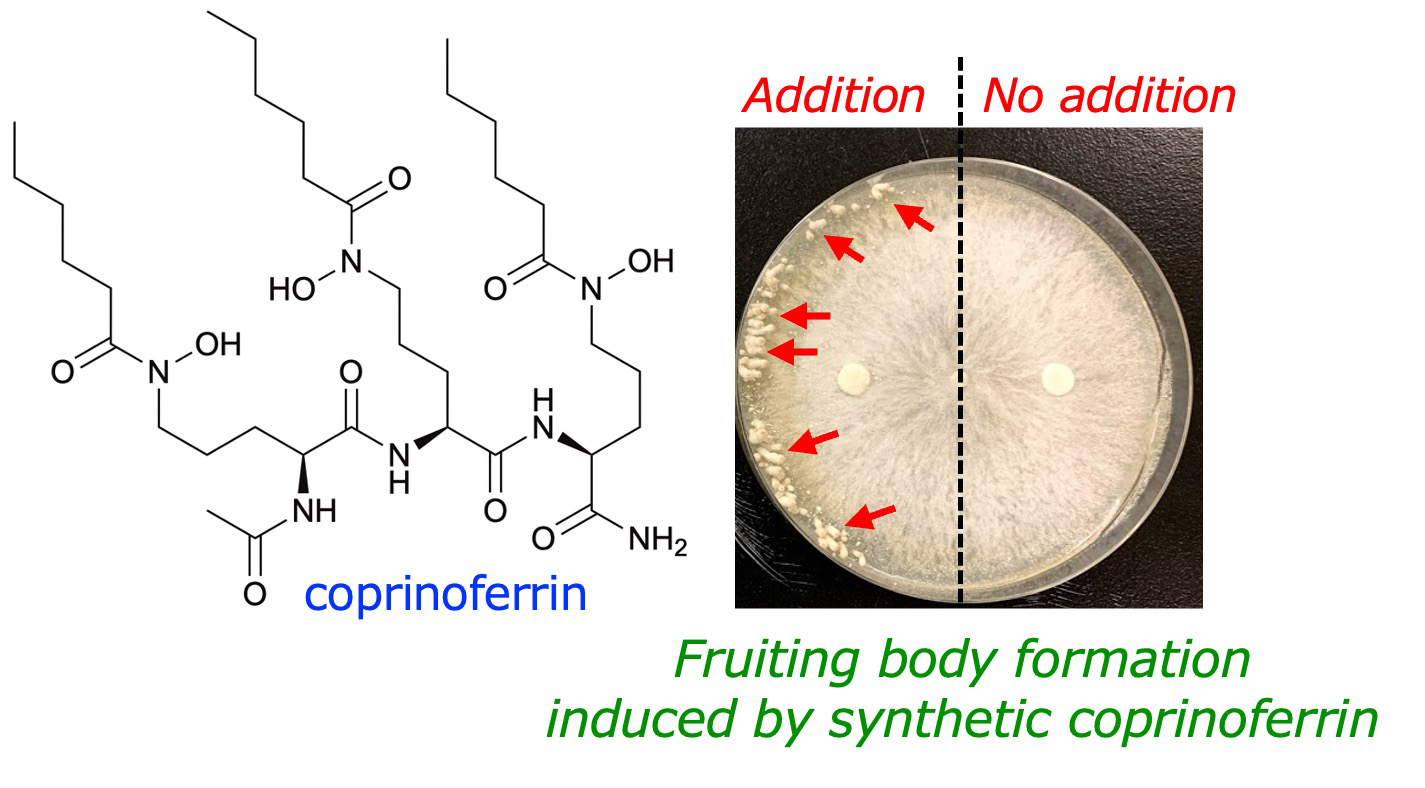

原著論文 Papers
2025
Toward the Synthesis of Strychnos Alkaloids: Effective Construction of Fused Cyclohexane and Pyrrolidine Portion of the Strychnos Skeleton via Domino Intermolecular and Intramolecular SN2 Cyclization
Tadahiro Hosoda, Tomohiro Tsutsumi, Ichiro Hayakawa*
Chem. Pharm. Bull. 2025, 73 (1), 46–57.
DOI: 10.1248/cpb.c24-00783
*Highlighted in Featured Article of Chemical and Pharamceutical Bulletin.
*Highlighted in Org. Chem. Highlights 2025, November 10.

2024
Efficient Oxidation with Singlet Oxygen from 5,10,15,20-Tetraphenylporphyrin under Blue LED Irradiation and Air Atmosphere: Simplified Preparation of Key Building Blocks for Natural Product Synthesis
Masato Hasumi, Tomohiro Tsutsumi, Daiki Shikama, Ichiro Hayakawa*
Synthesis 2024, 56 (20), 3215–3219.
DOI: 10.1055/a-2361-0069

Construction of hydroindole skeleton by photocatalytic oxidative dearomatization and cyclization sequence, and a concise synthesis of melodamide A and (±)-toussaintine C
Tomohiro Tsutsumi, Ryui Yamagami, Ichiro Hayakawa*
J. Org. Chem. 2024, 89 (12), 8931–8936.
DOI: 10.1021/acs.joc.4c00818
*Highlighted in Org. Chem. Highlights 2024, November 18.

Synthesis and biological evaluation of coprinoferrin, an acylated tripeptide hydroxamate siderophore
Ichiro Hayakawa,* Tomoki Isogai, Jun Takanishi, Shihori Asai, Chika Ando, Tomohiro Tsutsumi, Kenji Watanabe,* Akira Sakakura,* Yuta Tsunematsu*
Org. Biomol. Chem. 2024, 22 (4), 831–837.
DOI: 10.1039/D3OB01850D
2022
Structure–Activity Relationship Studies on an Antitumor Marine Macrolide Using Aplyronine A–Swinholide A Hybrid
Takayuki Ohyoshi,* Atsuhiro Takano, Imari Kikuchi, Tomotaka Ogura, Mayu Namiki, Yuto Miyazaki, Takahiro Hirano, Shota Konishi, Yuta Ebihara, Koichi Takeno, Ichiro Hayakawa, Hideo Kigoshi*
Org. Biomol. Chem. 2022, 20 (14), 2922–2938.
DOI: 10.1039/D2OB00118G
*Highlighted in Synfacts, 2022 (18), 0797.
2021
Toward the Synthesis of Paspaline-type Indole-terpenes: Stereoselective Construction of Core Scaffold with Contiguous Asymmetric Quaternary Carbon Centers
Ichiro Hayakawa,* Naochika Matsumaru, Akira Sakakura*
J. Org. Chem. 2021, 86 (14), 9802–9810.
DOI: 10.1021/acs.joc.1c01193

Takeo Usui,* Haruna Ebisu, Kana Shintani, Takumi Chinen,* Yoko Nagumo, Shuya Shioda, Taisei Hatanaka, Akira Sakakura, Ichiro Hayakawa, Hideo Kigoshi
Front. Pharmacol. 2021, 11, 620185.
DOI: 10.3389/fphar.2020.620185
2020
Quantitative analysis of the Tricholoma ustale-derived toxin, ustalic acid, in mushroom and food samples by LC–MS/MS
Naoki Yoshioka,* Ichiro Hayakawa, Tomiaki Minatani, Junko Tomozawa, Hiroyuki Akiyama, Hiroto Yomo
Forensic Sci. Int. 2020, 317, 110554.
DOI: 10.1016/j.forsciint.2020.110554
Kinetic Resolution of α-Nitrolactones by Catalytic Asymmetric Hydrolysis or Ester–Amide Exchange Reaction
Ryota Nakao, Yudai Fujii, Ichiro Hayakawa, Haruki Mizoguchi, Akira Sakakura*
Synlett 2020, 31 (20), 2018–2022.
DOI: 10.1055/s-0040-1707303
Enantioselective Diels–Alder Reaction of 3-Nitrocoumarins Promoted by Chiral Organoammonium Salt Catalysts
Yudai Fujii, Ryota Nakao, Saki Sugihara, Keita Fujita, Yuya Araki, Takayuki Kudoh, Ichiro Hayakawa, Haruki Mizoguchi, Akira Sakakura*
Synlett 2020, 31 (20), 2013–2017.
DOI: 10.1055/s-0040-1707302
Structure optimization of gatastatin for the development of γ-tubulin-specific inhibitor
Kana Shintani, Haruna Ebisu, Minagi Mukaiyama, Taisei Hatanaka, Takumi Chinen, Daisuke Takao, Yoko Nagumo, Akira Sakakura, Ichiro Hayakawa,* Takeo Usui*
ACS Med. Chem. Lett. 2020, 11 (6), 1125–1129.
DOI: 10.1021/acsmedchemlett.9b00526

2019
Toward the Synthesis of SB-203207: Construction of Four Contiguous Nitrogen-Containing Stereogenic Centers
Ichiro Hayakawa,* Anna Nagayasu, Akira Sakakura*
J. Org. Chem. 2019, 84 (23), 15614–15623.
DOI: 10.1021/acs.joc.9b02627

Toward the Synthesis of Yuzurimine-type Alkaloids: Stereoselective Construction of the Heterocyclic Portions of Deoxyyuzurimine and Macrodaphnine
Ichiro Hayakawa,* Ryosuke Nagatani, Masaki Ikeda, Dong-eun Yoo, Keita Saito, Hideo Kigoshi, Akira Sakakura*
Org. Lett. 2019, 21 (16), 6337–6341.
DOI: 10.1021/acs.orglett.9b02232

Catalytic Enantioselective Hosomi–Sakurai Reaction of α-Ketoesters Promoted by Chiral Copper(II) Complexes
Yutaro Niwa, Mayu Miyake, Ichiro Hayakawa, Akira Sakakura*
Chem. Commun. 2019, 55 (27), 3923–3926.
DOI: 10.1039/C9CC01159E
Structure–activity relationship study of gatastatin based on the Topliss tree approach
Ichiro Hayakawa,* Shuya Shioda, Takumi Chinen, Takeo Usui, Hideo Kigoshi*
Heterocycles 2019, 99 (1), 238–247.
DOI: 10.3987/COM-18-S(F)16
*HETEROCYCLES Special Issue Vol. 99 in hornor of Professor Tohru Fukuyama on 70th Birthday

2018
Development of a novel inducer of protein–protein interactions based on aplyronine A
Takayuki Ohyoshi, Atsuhiro Takano, Mayu Namiki, Tomotaka Ogura, Yuto Miyazaki, Yuta Ebihara, Koichi Takeno, Ichiro Hayakawa,* Hideo Kigoshi*
Chem. Commun. 2018, 54 (68), 9537–9540.
DOI: 10.1039/C8CC04613A

2017
Reinvestigation of the Biomimetic Cyclization of 3,5-Diketoesters: Application to the Total Synthesis of Cyercene A, an α-Methoxy-γ-Pyrone-Containing Polypropionate
Kai Onda, Ichiro Hayakawa, Akira Sakakura*
Synlett 2017, 28 (13), 1596–1600.
DOI: 10.1055/s-0036-1588795
Regioselective DMAD-insertion reaction of silyl dienol ether of γ-pyrone under catalyst- and heating-free conditions
Ichiro Hayakawa,* Yuji Yamanaka, Koichi Mitsudo, Hiromi Ota, Akira Sakakura*
Heterocycles 2017, 94 (12), 2299–2306.
DOI: 10.3987/COM-17-13820

Total synthesis of biselide E, a marine polyketide
Ichiro Hayakawa,* Kazuaki Suzuki, Masami Okamura, Shota Funakubo, Yuto Onozaki, Dai Kawamura, Takayuki Ohyoshi, Hideo Kigoshi*
Org. Lett. 2017, 19 (20), 5713–5716.
DOI: 10.1021/acs.orglett.7b03009

Stimulation of microtubule-based transport by nucleation of microtubules on pigment granules
Irina Semenova,* Dipika Gupta,* Takeo Usui, Ichiro Hayakawa, Ann Cowan,* Vladimir Rodionov*
Mol. Biol. Cell. 2017, 28 (11), 1418–1425.
DOI: 10.1091/mbc.E16-08-0571
Total synthesis of biselide A, a cytotoxic macrolide of marine origin
Ichiro Hayakawa,* Masami Okamura, Kazuaki Suzuki, Mami Shimanuki, Kizuku Kimura, Takuya Yamada, Takayuki Ohyoshi, Hideo Kigoshi*
Synthesis 2017, 49 (13), 2958–2970.
DOI: 10.1055/s-0036-1588169

Second-generation total synthesis of aplyronine A featuring Ni/Cr-mediated coupling reaction
Ichiro Hayakawa,* Keita Saito, Sachiko Matsumoto, Shinichi Kobayashi, Ayaka Taniguchi, Kenichi Kobayashi, Yusuke Fujii, Takahiro Kaneko, Hideo Kigoshi*
Org. Biomol. Chem. 2017, 15 (1), 124–131.
DOI: 10.1039/C6OB02241C
*Highlighted in “2017 Hot Articles in Organic and Biomolecular Chemistry”.

2016
Total synthesis of natural derivative and artificial analogs of 13-oxyingenol and their biological evaluation
Takayuki Ohyoshi, Yuki Tamura, Ichiro Hayakawa,* Go Hirai,* Yamato Miyazawa, Shota Funakubo, Mikiko Sodeoka,* Hideo Kigoshi*
Org. Biomol. Chem. 2016, 14 (48), 11426–11437.
DOI: 10.1039/C6OB02268E

Discovery of O6-benzyl glaziovianin A, a potent cytotoxic substance and a potent inhibitor of α,β-tubulin polymerization
Ichiro Hayakawa,* Shuya Shioda, Takumi Chinen, Taisei Hatanaka, Haruna Ebisu, Akira Sakakura, Takeo Usui,* Hideo Kigoshi*
Bioorg. Med. Chem. 2016, 24 (21), 5639–5645.
DOI: 10.1016/j.bmc.2016.09.026

2015
The γ-tubulin specific inhibitor gatastatin reveals temporal requirements of microtubule nucleation during the cell cycle
Takumi Chinen, Peng Liu, Shuya Shioda, Judith Pagel, Berati Cerikan, Tien-chen Lin, Oliver Gruss, Yoshiki Hayashi, Haruka Takeno, Tomohiro Shima, Yasushi Okada, Ichiro Hayakawa, Yoshio Hayashi, Hideo Kigoshi, Takeo Usui,* Elmar Schiebel*
Nature Communications 2015, 6 (10), 8722.
DOI: 10.1038/ncomms9722
*Highlighted in F1000Prime
Synthesis and structure-activity relationships for cytotoxicity and apoptosis-inducing activity of (+)-halichonine B
Ichiro Hayakawa,* Tomomi Nakamura, Osamu Ohno, Kiyotake Suenaga, Hideo Kigoshi*
Org. Biomol. Chem. 2015, 13 (39), 9969–9976.
DOI: 10.1039/C5OB01488C
*Jin-Quan Yu, Lei Liu and OBC’s other Associate Editors choose their best articles of 2016: Professor Margaret Brimble’s recommended articles

Construction of the [6–7–5–5] tetracyclic core, all the carbocyclic framework of yuzurimine-type alkaloids
Ichiro Hayakawa,* Keisuke Niida, Hideo Kigoshi*
Chem. Commun. 2015, 51 (58), 11568–11571.
DOI: 10.1039/C5CC03479E

2014
Practical synthesis of glaziovianin A, a cytotoxic isoflavone, and its O7-propargyl analogue
Ichiro Hayakawa,* Shuya Shioda, Akiyuki Ikedo, Hideo Kigoshi*
Bull. Chem. Soc. Jpn. 2014, 87 (4), 544–549.
DOI: 10.1246/bcsj.20130342

2013
Glaziovianin A prevents endosome maturation via inhibiting microtubule dynamics
Takumi Chinen, Sayaka Kazami, Yoko Nagumo, Ichiro Hayakawa, Akiyuki Ikedo, Masatoshi Takagi, Akihito Yokosuka, Naoko Imamoto, Yoshihiro Mimaki, Hideo Kigoshi, Hiroyuki Osada, Takeo Usui*
ACS Chem. Biol. 2013, 8 (5), 884–889.
DOI: 10.1021/cb300641h
2012
Design, synthesis, and biological evaluation of the analogues of glaziovianin A, a potent antitumor isoflavone
Ichiro Hayakawa,* Akiyuki Ikedo, Takumi Chinen, Takeo Usui, Hideo Kigoshi*
Bioorg. Med. Chem. 2012, 20 (19), 5745–5756.
DOI: 10.1016/j.bmc.2012.08.005

Total synthesis and biological evaluation of auripyrones A and B
Ichiro Hayakawa, Takuma Takemura, Emi Fukasawa, Yuta Ebihara, Natsuki Sato, Takayasu Nakamura, Kiyotake Suenaga, Hideo Kigoshi*
Bull. Chem. Soc. Jpn. 2012, 85 (10), 1077–1092.
DOI: 10.1246/bcsj.20120162
*BCSJ Award Article (2012).
Toward the synthesis of γ-pyrone-containing natural products: diastereoselective aldol-type reaction of a γ-pyrone
Takuma Takemura, Ichiro Hayakawa, Emi Fukasawa, Tetsuya Sengoku, Hideo Kigoshi*
Tetrahedron 2012, 68 (32), 6477–6484.
DOI: 10.1016/j.tet.2012.05.111
Total synthesis of (–)-13-oxyingenol and its natural derivative
Takayuki Ohyoshi, Shota Funakubo, Yamato Miyazawa, Keisuke Niida, Ichiro Hayakawa, Hideo Kigoshi*
Angew. Chem. Int. Ed. 2012, 51 (20), 4972–4975.
DOI: 10.1002/anie.201201383
*Highlighted in Synfacts 2012, (8), 816.
Design, synthesis, and biological evaluations of aplyronine A–mycalolide B hybrid compound
Kenichi Kobayashi, Yusuke Fujii, Yuichiro Hirayama, Shinichi Kobayashi, Ichiro Hayakawa, Hideo Kigoshi*
Org. Lett. 2012, 14 (5), 1290–1293.
DOI: 10.1021/ol300182r
Synthetic studies toward biselides. part 2: synthesis of the macrolactone part of biselides A and B using allylic oxidation
Yohsuke Satoh, Takuya Yamada, Yuto Onozaki, Dai Kawamura, Ichiro Hayakawa, Hideo Kigoshi*
Tetrahedron Lett. 2012, 53 (11), 1393–1396.
DOI: 10.1016/j.tetlet.2012.01.021
Synthetic studies toward biselides. part 1: synthesis of the core carbon framework of biselides A, B, and E using Stille coupling
Yohsuke Satoh, Dai Kawamura, Masashi Yamaura, Yoichi Ikeda, Yumi Ochiai, Ichiro Hayakawa, Hideo Kigoshi*
Tetrahedron Lett. 2012, 53 (11), 1390–1392.
DOI: 10.1016/j.tetlet.2012.01.020
2011
Synthetic studies toward 13-oxyingenol: construction of the fully substituted tetracyclic compound
Takayuki Ohyoshi, Yamato Miyazawa, Kenta Aoki, Satomi Ohmura, Yuki Asuma, Ichiro Hayakawa, Hideo Kigoshi*
Org. Lett. 2011, 13 (9), 2160-2163.
DOI: 10.1021/ol103151k
Toward the second generation synthesis of aplyronine A: stereocontrolled assembly of the C1–C19 segment by using an asymmetric Nozaki-Hiyama-Kishi coupling
Kenichi Kobayashi, Yusuke Fujii, Ichiro Hayakawa, Hideo Kigoshi*
Org. Lett. 2011, 13 (5), 900–903.
DOI: 10.1021/ol1029657
Synthetic studies towards optically active 13-oxyingenol via asymmetric cyclopropanation
Ichiro Hayakawa, Yamato Miyazawa, Takayuki Ohyoshi, Yuki Asuma, Kenta Aoki, Hideo Kigoshi*
Synthesis 2011, (5), 769–777.
DOI: 10.1055/s-0030-1259430
2010
Structure–activity relationship study of glaziovianin A against cell cycle progression and spindle formation of HeLa S3 cells
Akiyuki Ikedo, Ichiro Hayakawa, Takeo Usui, Sayaka Kazami, Hiroyuki Osada, Hideo Kigoshi*
Bioorg. Med. Chem. Lett. 2010, 20 (18), 5402–5404.
DOI: 10.1016/j.bmcl.2010.07.111
Total synthesis of auripyrones A and B and determination of the absolute configuration of auripyrone B
Ichiro Hayakawa, Takuma Takemura, Emi Fukasawa, Yuta Ebihara, Natsuki Sato, Takayasu Nakamura, Kiyotake Suenaga, Hideo Kigoshi*
Angew. Chem. Int. Ed. 2010, 49 (13), 2401–2405.
DOI: 10.1002/anie.200906662
*Highlighted in Synfacts 2010, (7), 738.
2009
Total synthesis and cytotoxicity of haterumalides NA and B and their artificial analogues
Mitsuru Ueda, Masashi Yamaura, Yoichi Ikeda, Yuta Suzuki, Kensaku Yoshizato, Ichiro Hayakawa, Hideo Kigoshi*
J. Org. Chem. 2009, 74 (9), 3370–3377.
DOI: 10.1021/jo802806z
*Highlighted in Synfacts 2010, (1), 9.
Practical syntheses of enantiomerically pure key intermediates of opioid receptor-like 1 (ORL1) antagonists
Takashi Yoshizumi,* Akio Ohno, Tomohiro Tsujita, Hirobumi Takahashi, Osamu Okamoto, Ichiro Hayakawa, Hideo Kigoshi*
Synthesis 2009, (7), 1153–1162.
DOI: 10.1055/s-0028-1087989
Aldol-type reaction of a 4-pyrone: a straightforward approach to 4-pyrone-containing natural products
Tetsuya Sengoku, Takuma Takemura, Emi Fukasawa, Ichiro Hayakawa, Hideo Kigoshi*
Tetrahedron Lett. 2009, 50 (3), 325–328.
DOI: 10.1016/j.tetlet.2008.11.017
2008
Structure of zamamistatin - a correction
Masaki Kita, Yuta Tsunematsu, Ichiro Hayakawa, Hideo Kigoshi*
Tetrahedron Lett. 2008, 49 (37), 5383–5384.
DOI: 10.1016/j.tetlet.2008.06.125
Synthesis of ustalic acid, an inhibiter of Na+,K+-ATPase
Ichiro Hayakawa, Hidekazu Watanabe, Hideo Kigoshi*
Tetrahedron 2008, 64 (25), 5873–5877.
DOI: 10.1016/j.tet.2008.04.051
Second-generation total synthesis of haterumalide NA using B-alkyl Suzuki–Miyaura coupling
Ichiro Hayakawa, Mitsuru Ueda, Masashi Yamaura, Yoichi Ikeda, Yuta Suzuki, Kensaku Yoshizato, Hideo Kigoshi*
Org. Lett. 2008, 10 (9), 1859–1862.
DOI: 10.1021/ol800554f
2007
Synthetic studies on mycalolide B: synthesis of the C7–C35 fragment
Tomoyuki Kimura, Satomi Kuribayashi, Tetsuya Sengoku, Keita Matsui, Shoko Ueda, Ichiro Hayakawa, Kiyotake Suenaga, Hideo Kigoshi*
Chem. Lett. 2007, 36 (12), 1490–1491.
DOI: 10.1246/cl.2007.1490
Synthesis of glaziovianin A: a potent antitumor isoflavone
Ichiro Hayakawa, Akiyuki Ikedo, Hideo Kigoshi*
Chem. Lett. 2007, 36 (11), 1382–1383.
DOI: 10.1246/cl.2007.1382
Synthetic study on 13-oxyingenol: construction of the full carbon frame work
Ichiro Hayakawa, Yuki Asuma, Takayuki Ohyoshi, Kenta Aoki, Hideo Kigoshi*
Tetrahedron Lett. 2007, 48 (35), 6221–6224.
DOI: 10.1016/j.tetlet.2007.06.135
2006
Enatioselective synthesis of aurisides A and B, cytotoxic macrolide glycosides of marine origin
Kiyotake Suenaga, Hiroshi Hoshino, Takanori Yoshii, Kazunori Mori, Hiroki Sone, Yuhki Bessho, Akira Sakakura, Ichiro Hayakawa, Kiyoyuki Yamada, Hideo Kigoshi*
Tetrahedron 2006, 62 (33), 7687–7698.
DOI: 10.1016/j.tet.2006.05.077
Revised structure of zamamistatin
Ichiro Hayakawa, Toshiaki Teruya, Hideo Kigoshi*
Tetrahedron Lett. 2006, 47 (2), 155–158.
DOI: 10.1016/j.tetlet.2005.10.157
2004
Synthesis of the tricyclic core of halichlorine
Ichiro Hayakawa, Hirokazu Arimoto,* Daisuke Uemura
Chem. Commun. 2004, (10), 1222–1223.
DOI: 10.1039/b402130d
2003
Synthesis of (+/–)-pinnaic acid
Ichiro Hayakawa, Hirokazu Arimoto,* Daisuke Uemura
Heterocycles 2003, 59 (2), 441–444.
DOI: 10.3987/COM-02-S45
1999
Three new alkaloids, convolutamines F and G, and convolutamydine E, from the Floridian marine bryozoan Amathia convoluta
Yoshiaki Kamano,* Ayano Kotake, Hirofumi Hashima, Ichiro Hayakawa, Hatsue Hiraide, Hui-ping Zhang, Haruhisa Kizu, Kanki Komiyama, Masahiko Hayashi, George R. Pettit
Collect. Czech. Chem. Commun. 1999, 64 (7), 1147–1153.
DOI: 10.1135/cccc19991147
Multi-valent polymer of vancomycin: enhanced antibacterial activity against VRE
Hirokazu Arimoto,* Kazuya Nishimura, Tomoya Kinumi, Ichiro Hayakawa, Daisuke Uemura
Chem. Commun. 1999, (15), 1361–1362.
DOI: 10.1039/a903529j
*Highlighted in Chemical & Engineering News 1999, 77 (32), 7.
1998
Absolute stereochemistry of halichlorine; a potent inhibitor of VCAM-1 induction
Hirokazu Arimoto,* Ichiro Hayakawa, Makoto Kuramoto, Daisuke Uemura
Tetrahedron Lett. 1998, 39 (8), 861–862.
DOI: 10.1016/s0040-4039(97)10714-6